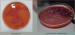
SS-агар

SS-агар
SS-агар сухой
Питательная среда для выделения сальмонелл и шигелл из исследуемого материала и их дифференциации от других энтеробактерий по признаку ферментации лактозы.
Данный продукт имеет Регистрационное Удостоверение.
Фасовка 250 г для приготовления 3,6 л среды.
Срок годности 2 года.
- Стерильность: -
- Форма выпуска: Порошок
- Упаковка: 250 г
- Документы: Регистрационное Удостоверение